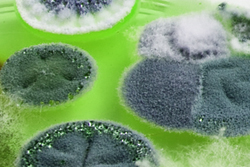

- info@acelabo.com
- +1-450-693-0764
Qualité de l'air

Qu'est-ce que c'est
La moisissure est un terme utilisé pour désigner les champignons de faible hauteur qui envahissent et détruisent les biens et bâtiments. Les moisissures sont des saprophytes omniprésentes : elles croissent dans notre environnement intérieur et extérieur en se nourrissant de la matière organique en décomposition qui nous entoure.
Lorsque la moisisure atteint sa maturité, elle produit des spores (les propagules) qui se propagent dans l'air ambiant afin de coloniser les surfaces environnantes. D’ordinaire, les espèces retrouvés à l’extérieur se retrouvent également à l’intérieur des bâtiments, mais à des concentrations inférieures, notamment si les fenêtres sont maintenues fermées ou si l’immeuble est ventilé mécaniquement.
Dangers pour la santé
Selon l'espèce de moisissure et les conditions de santé de chaque individu, les effets sur la santé d'une exposition aux moisisures peuvent varier d'une simple réaction allergique à des réactions immunologiques et infections graves.
Réglementation
Il n'existe actuellement aucun seuil réglementaire en matière d'exposition aux moisissures. Il est néanmoins reconnu que la mycoflore de l’air intérieur du bâtiment devrait être qualitativement similaire et quantitativement inférieure à l’air extérieur.
Quand demander cette analyse
Plusieurs raisons peuvent justifier une demande d’analyse des moisissures dans l’air ambiant, notamment :
- Lorsque le bâtiment a subi des dommages causés par l’eau
- Lorsque les habitants rapportent des problèmes de santé récurrents
- Pour des causes légales ou des conflits (ex: vices cachés, qualité des travaux entrepris par des entrepreneurs, etc.)
- Lors de l’achat d’une propriété immobilière
- Pour faire le suivi sur des travaux de décontamination.
Analyse et résultats
L'analyse des moisisures dans l'air ambiant se décline en 2 types:
L'analyse des moisissures totales (viables et non-viables) par la microscopie : Cette méthode permet d'établir la concentration en moisissures totales dans l'air ambiant tout en déterminant les genres de moisissures viables et non-viables qui s'y retrouvent. L'échantillonnage doit être effectué selon un volume contenu d'air et une cassette de type trappes à spores (Allergenco-D ou Air-O-Cell).
- Avantages de cette méthode : 1) résultats rapides (la journée même au besoin) et 2) permet la détection des moisssures viables ainsi que des moisissures non-viables qui peuvent affecter la santé des occupants, et 3) les échantillons ne nécessitent aucune condition de manutention ni de conservation particulière.
- Inconvénients de cette méthode: 1) l'identification des moisissures est limitée au genre, 2) aucune distinction entre la proportion de cellules viables versus non-viables, et 3) possibilité de sous-estimer la contamination réelle de la surface si le prélèvement n'est pas fait adéquatement (méthode notamment peu recommandée pour des surfaces irrégulières telles que le béton).
L'analyse des moisissures viables et cultivables par la culture : Cette méthode permet d'établir la concentration en moisissures viables cultivables dans l'air ambiant tout en déterminant les espèces de moisissures qui s'y retrouvent. Le prélèvement doit être effectué selon un volume contenu d'air et par impaction sur gélose à l'aide d'un impacteur Andersen.
- Avantages de cette méthode : 1) permet une identification à l'espèce et 2) permet la détection de moisssures viables donc actives et pouvant croître.
- Inconvénients de cette méthode: 1) le délai de culture varie de 10-14 jours, 2) seule la portion viable cultivable est détectée ce qui représente un faible pourcentage des particules fongiques totales et 3) les échantillons doivent être maintenues au frais et transmis au laboratoire dans un délais de 48h suivant l'échantillonnage.
Les méthodes utilisées pour l'analyse des moisssures ont été développées à partir des méthodes analytiques de l’IRSST.
ACE Laboratoires sont accrédités et reconnus compétents par l’AIHA par le biais du programme trimestriel d’essais d’aptitude de l’EMPAT (examen direct).